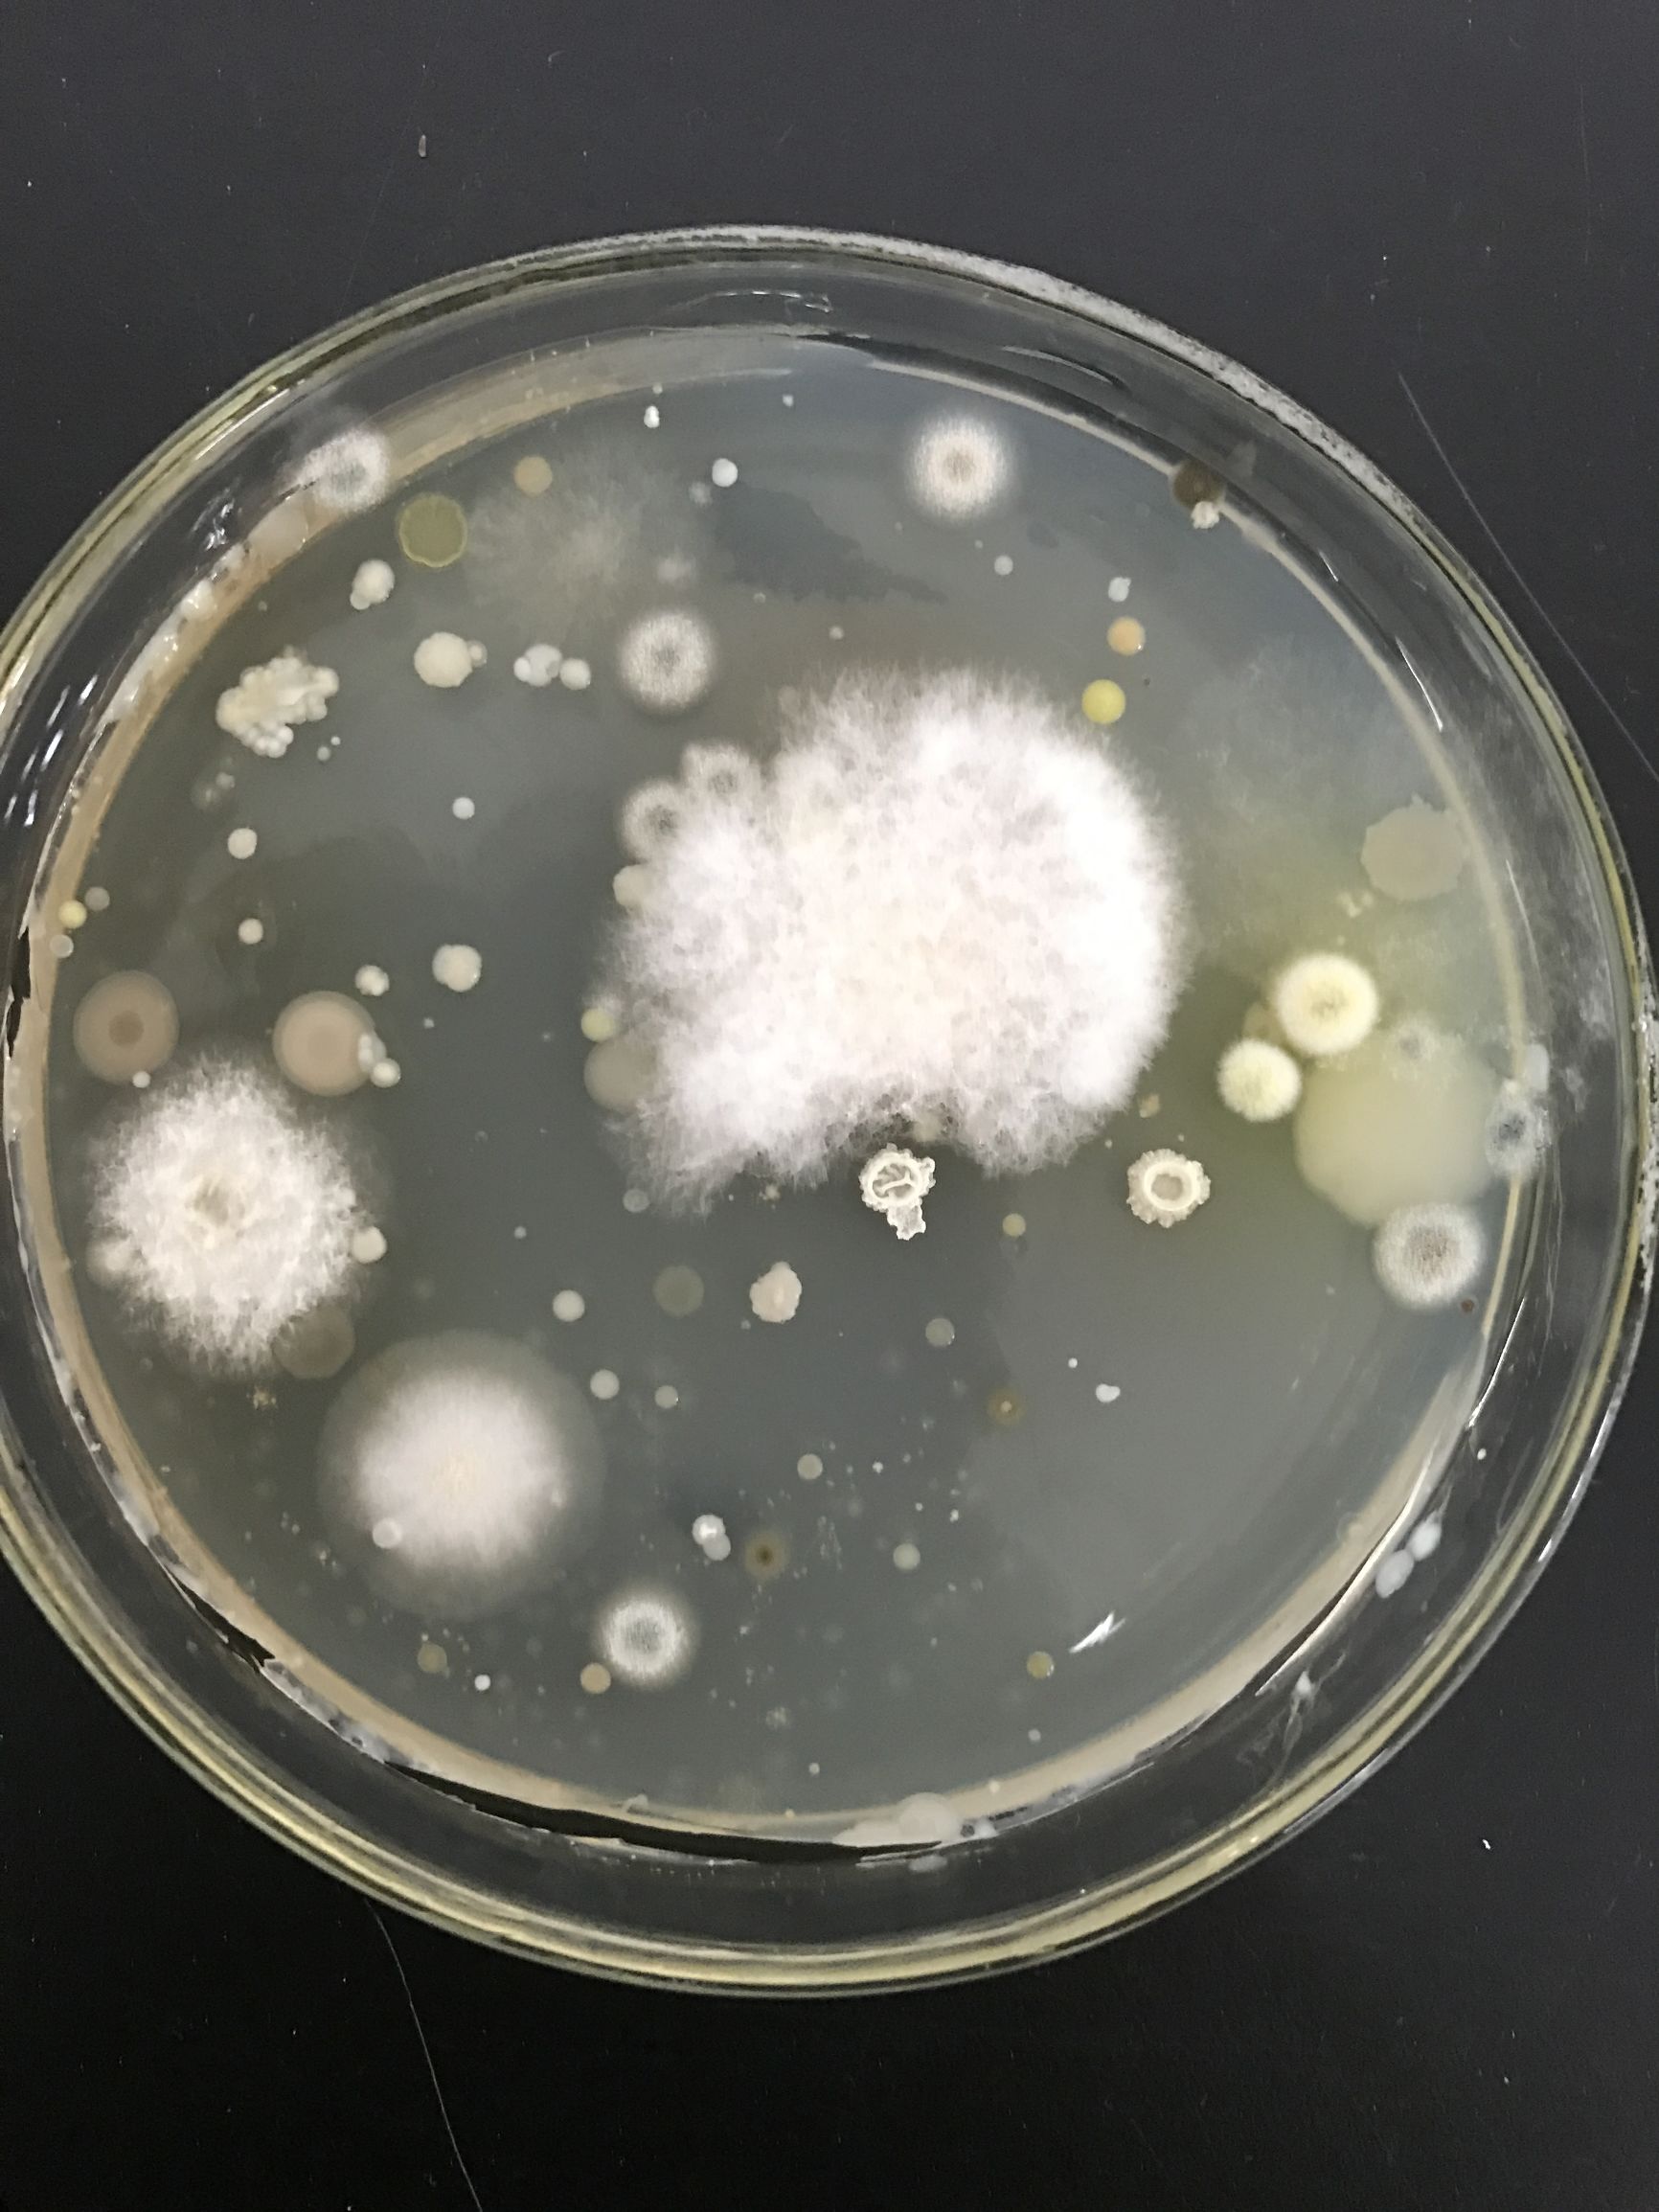
原来脚气菌长这样，三招教你治脚气

脚气,相信很多人都不陌生。它又称为足癣,是发生于足跖部、趾间皮肤的皮肤癣菌感染,有时可延及到足跟及足背,但仅发生于足背者称体癣。很多人都被脚气折磨的痛不欲生,那他到底长什么样呢?下面小编就为大家介绍一下脚气真菌。

引起脚气的真菌叫皮肤癣菌, 是一种喜欢生活在皮肤角质层中的真菌。它们有一些生活在土壤里,称为亲土性真菌;有一些生活在动物皮毛上,称为亲动物性真菌;另一些自然生活在人的皮毛中,称为亲人性真菌。
 在显微镜下皮癣真菌的菌丝结构。
在显微镜下皮癣真菌的菌丝结构。
把脚气菌放在培养基里培养,两天后就会长成一大片,一簇一簇的菌丝生长在一起。
造成我们脚气的就是这些白白的菌丝,他们大量的繁殖在我们的皮肤里,对我们的生活造成了很大的影响。
造成我们脚气的就是这些白白的菌丝,他们大量的繁殖在我们的皮肤里,对我们的生活造成了很大的影响。
得了脚气不可怕,脚气菌离开了潮湿的环境很快就会死掉,所以要常常保持脚部干燥。
每天洗脚,得了脚气很容易引发脚臭,常常洗脚可以减轻脚气症状。
 每天换袜子,潮湿的袜子里隐藏着很多脚气菌,将洗干净的袜子在太阳底下暴晒,或者用开水烫袜子,就不会再有脚气菌了。
每天换袜子,潮湿的袜子里隐藏着很多脚气菌,将洗干净的袜子在太阳底下暴晒,或者用开水烫袜子,就不会再有脚气菌了。
 鞋子不用经常洗,两天换鞋子,不穿的鞋子在太阳下暴晒就能杀死脚气菌。
鞋子不用经常洗,两天换鞋子,不穿的鞋子在太阳下暴晒就能杀死脚气菌。
 得了脚气不可怕,勤快就能把病治。
得了脚气不可怕,勤快就能把病治。